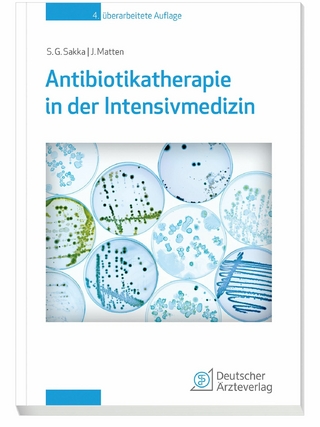
Antibiotikatherapie in der Intensivmedizin

Buch | Softcover
2025
|
Auflage:
4
|
Cambridge University Press
ISBN: 9781009470155
CHF 104,70 (inkl. MwSt)
- Versand in
10-20 Tagen